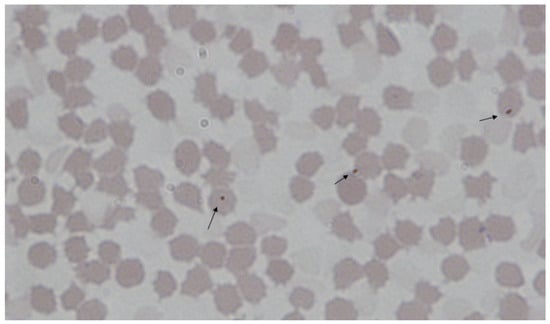
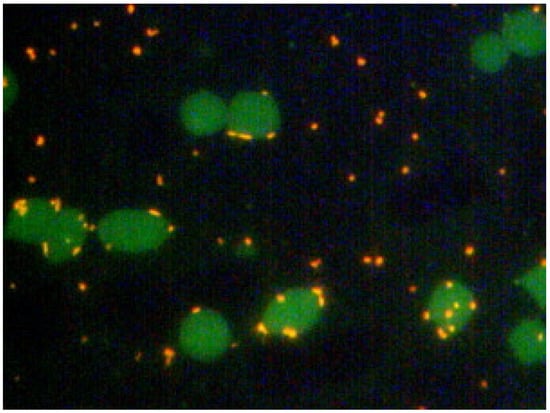

Abstract
Haemotrophic mycoplasmas (haemoplasmas) are a group of highly specific and adapted bacteria. Three different haemoplasma species in pigs are known to date: Mycoplasma (M.) suis, M. parvum and ‘Candidatus (Ca.) M. haemosuis’. Even though these bacteria have been known in pig farming for a long time, it is difficult to draw general conclusions about the relevance of their infections in pigs. This review summarizes the current knowledge on the three porcine haemoplasma species with regards to clinical and pathological descriptions, pathobiology, epidemiology and diagnostics as well as prevention and therapy. Overall, it is clear that considerably more data are available for M. suis than for the other two species, but generally, porcine haemoplasmas were found to be highly prevalent all over the world. Mycoplasma suis is the most virulent species, causing acute infectious anaemia in pigs (IAP), whereas M. parvum usually results in chronic and subclinical infections associated with performance losses. Little is known about the clinical significance of the recently discovered third porcine species ‘Ca. M. haemosuis’. So far, the described pathogenic mechanisms mainly include direct destruction of erythrocytes via adhesion, invasion, eryptosis and nutrient scavenging, indirect erythrocyte lysis due to immune-mediated events and immune dysregulation processes. A review of published diagnostic data confirms PCR assays as the current standard method, with various cross-species and species-specific protocols. Overall, there is a need for further examination to obtain valuable insights for practical application, specifically regarding the importance of subclinical infections in naturally infected animals. An essential requirement for this will be to gain a more comprehensive understanding of the mechanisms operating between the host and the pathogen.
1. Introduction
Haemotrophic mycoplasmas (haemoplasmas) are a group of cell-wall-less, small and pleomorphic bacteria occurring in the blood of their mammal hosts [1]. They attach to or invade erythrocytes, whereas parasitism outside of the blood has not yet been discovered [1,2,3]. Haemoplasmas are defined as highly adapted to the blood environment and strictly depend on their hosts, especially considering that the degradation of glucose seems to be the only complete pathway for self-sufficient energy metabolism [1,4]. Despite the fact that haemoplasmas have been known for almost 100 years, they still cannot be cultivated in vitro, which presents a major challenge in gaining knowledge on the pathobiology of these organisms as well as in the establishment of therapeutic and preventive measures [2,5,6]. Several haemoplasma species are described in various mammal hosts, including farm animals, wild animals and humans [1,7]. The taxonomy of haemoplasmas has been revised in the past and is still not yet completed. Haemoplasmas were initially differentiated into two different genera–Eperythrozoon and Haemobartonella. Based on sequence analyses of the 16S rRNA and RNase P genes, the genera were reclassified from the order Rickettsiales, family Anaplasmataceae, into the order Mycoplasmatales, family Mycoplasmataceae, genus Mycoplasma [8,9,10,11,12,13]. Phylogenetic analysis revealed a clear separation of the haemoplasmas from the other mycoplasma species into their own cluster. Within this cluster, demarcation of two subgroups can be seen, with one of the subgroups containing the haemoplasma species formerly assigned to the genus Eperythrozoon (Suis group) and the other subgroup (Haemofelis group) containing the representatives of the former genus Haemobartonella [13,14,15,16]. In 2018, a revision of the taxonomy, with the creation of a new genus, was proposed by Gupta et al.; however, this proposal has so far not been implemented [17]. The genome of haemoplasmas is quite small, harbouring between 547 and 1545 coding sequences (CDSs) [18]. A high percentage of the CDSs code for hypothetical proteins [18]. Analyses revealed major gaps in metabolic pathways, suggesting a very close adaption of haemoplasmas to their host environment [18].
Pigs are a well-known host and infections caused by porcine haemoplasma species are often of major relevance in the porcine health management and pig production sectors [19,20,21,22,23,24]. This review aims to summarize the current knowledge on haemoplasma infections in pigs, embracing the current taxonomy, clinical and pathological aspects as well as epidemiological descriptions and diagnostics.
2. Porcine Haemoplasma Species
To date, numerous haemoplasma species related to those that infect porcine have been described, with the first haemoplasma in pigs described in the 1930s [25,26]. The first species description was at the beginning of the 1950s when Splitter differentiated the two species Eperythrozoon (E.) suis and Eperythrozoon parvum [27,28], which are currently known as Mycoplasma (M.) suis and Mycoplasma parvum [9,10,29]. In 2017, a third haemoplasma species named ‘Candidatus (Ca.) Mycoplasma haemosuis’ was described in China [30]. Recently, Thongmeesee et al. have described the existence of a putative novel porcine haemoplasma species in Thailand [15]. Table 1 below lists the currently confirmed porcine haemoplasma species. In the phylogenetic cluster, M. suis, M. parvum and the putative novel species all belong to the “Suis group”, while ‘Ca. M. haemosuis’ is in the “Haemofelis group” [15,31].

Table 1.
Porcine haemoplasma species.
Complete genome sequences are available for M. suis and M. parvum, but not for ‘Ca. M. haemosuis’ [4,29,31,32]. Like other haemoplasmas, the genomes of both porcine species harbour a high percentage of CDSs with unknown function (hypothetical proteins), with 61.3% hypothetical proteins in M. suis strain Illinois [4], 64.6% in M. suis strain KI3806 [32] and 77% in M. parvum strain Indiana [29]. Interestingly, a comparison between M. suis strain Illinois and M. parvum strain Indiana showed that both species share all CDSs with known functions [33]. To gain more insights into the pathobiology of haemoplasmas as well as to understand differences in the pathogenicity of different species, haemoplasma hypothetical proteins should be a topic of further research. Further, full-genome analysis of the novel ‘Ca. M. haemosuis’ is essential.
3. Clinical and Pathological Descriptions
The following section provides an overview of published data describing the clinical and pathological pictures of individual porcine haemoplasmas. Available literature for M. suis is considerably more extensive than for the other two species. It can be summarized that porcine haemoplasmas are associated with acute and clinically apparent diseases, as well as with subclinical and most likely chronic diseases. All forms of diseases can contribute to economic losses in pig production [20,21,22,34].
Considering the acute form of the disease, M. suis is the causative infectious agent of infectious anaemia in pigs (IAP), a disease formerly known as porcine eperythrozoonosis (PE). ‘Ca. M. haemosuis’ was associated with IAP in two published cases but confirmation of pathogenicity in experimental infection is still pending [30,35]. Studies of M. parvum are not extensive and are very rare and old, leading to uncertainty about the capacity of M. parvum to cause acute IAP.
Data on the chronic form of infection are scarce, but implicate a negative impact of M. suis, and possibly M. parvum, on the performance and health of pigs. So far, no data has been published on the chronic form of ‘Ca. M. haemosuis’ infection. As presented in Chapter 5.2., the detection of the haemoplasma species in animals without obvious clinical signs indicates a widespread occurrence of subclinical or asymptomatic forms of the disease.
Co-infections with two or all three haemoplasma species have been described in subclinical animals in the field in a couple of cases [36,37,38,39]; however, the relevance of those co-infections has not been discussed in detail.
3.1. Mycoplasma suis
Clinical signs of M. suis infections have been comprehensively described. Experimental infections with M. suis in splenectomised pigs imitate the acute and severe form of IAP, as the absence of the spleen probably results in insufficient removal of M. suis-infected erythrocytes from the blood [3,40]. The cardinal signs of acute IAP are pallor and icterus of the skin and mucous membranes, both resulting from intravascular haemolysis [3,40,41,42,43,44]. Further, skin petechia or urticaria as well as necrosis and cyanoses of distal body parts, particularly of the ears, distal limbs and the tail can be observed [3,45]. Generalized haemorrhages of the skin are usually referred to as Morbus maculosus or purpura haemorrhagica [45]. In addition, unspecific signs of infections like high fever, apathy and an increased respiratory rate also occur [3,40,42,45]. In sows, dysgalactia, reproductive cycle disorders and abortion are described in the literature [23,43,46]. Laboratory findings of acute IAP are typically represented by a high number of M. suis cells in the blood (up to >1010/mL), as well as by normocytic, normochromic anaemia, increased bilirubin levels and hypoglycaemia [3,40,45,47,48]. Acute IAP is a life-threatening condition that can be fatal, especially in piglets, if no treatment is initiated [3,40]. Outbreaks of acute and severe IAP in the field seem to be rare and are attributed to certain stressors like weaning, parturition or re-grouping [49,50]. The severity of acute IAP in the field varies between individuals and different age groups, with younger animals usually developing more severe symptoms, whereas older animals often exhibit mild symptoms and may transition to the chronic form of the disease. Chronic infections are often subclinical/asymptomatic, though they can cause low-grade anaemia. Chronic infections are usually characterized by a much smaller number of pathogens in the blood compared to acute IAP [40,51]. Many authors consider infections with M. suis to be life-long [40,50].
Interestingly, M. suis infections appear to predispose the host to enteric and respiratory diseases, as described in older studies [52,53]. Pereyra et al. further stated a potential connection between M. suis infections and “postweaning multisystemic wasting syndrome” (PMWS), a condition associated with porcine circovirus type 2 (PCV 2) infection [54]. In addition, a negative impact of M. suis infections on performance parameters has been outlined. studies by Petri et al. and Sonalio et al. observed a negative correlation between the occurrence of haemoplasmas, including M. suis, and daily weight gain, slaughter weights and the number of weaned piglets [22,34]. Zinn et al. described reduced birth weights and reduced weights in 3-week-old piglets but no further effects on reproductive performance in M. suis-positive farms [24]. A more recent study showed significantly increased stillborn rates per litter in farms where M. suis was detected compared to M. suis-negative farms, but no significant changes concerning other reproductive parameters (i.e., number of live born piglets per sow, number of weaned piglets per sow or return to oestrus rate) [20]. Similarly, the study by Brissonnier et al. confirmed an increased rate of stillborn piglets in M. suis-infected gilts; however, significant negative impacts of M. suis on other production performance parameters were not obvious in sows [21].
The most frequently described pathomorphological findings in pigs who suffer from acute M. suis-induced IAP reflect the clinically observed icterus in various locations, such as the tunica intima of vessels [3,42,55,56]. As an example, Figure 1 illustrates the yellow discolouration of an aorta obtained from a pig infected with M. suis and suffering from acute IAP [3].

Figure 1.
Yellowish-icteric discolouration of the tunica intima of an aorta obtained from an M. suis-infected pig suffering from acute IAP [3] (published open access under a Creative Commons Attribution 4.0 International License: https://creativecommons.org/licenses/by/4.0/).
Macroscopic and microscopic evidence of disseminated intravascular coagulopathy, including hyaline vascular thrombi in organs and fibrin within lymph node sinuses, have been described [3]. Damage to the endothelial surface has also been described [57]. Table 2 provides a detailed summary of pathomorphological findings in pigs suffering from M. suis-induced IAP.

Table 2.
Macroscopic and microscopic abnormalities described in M. suis-infected pigs.
3.2. Mycoplasma parvum
A few studies on the pathogenicity of M. parvum have been published. According to these studies, this haemoplasma species does not cause severe infectious anaemia and is even considered non-pathogenic in pigs [33].
These studies were carried out on naturally infected pigs that were then splenectomised. Subsequently, bacteraemia is exaggerated, resulting in different clinical observations [27,33,60,61]. While two of these studies did not reveal any clinical signs in the infected pigs (age and usage unknown) following splenectomy [27,60], Jennings and Seamer reported that one out of seven infected animals (pigs less than 3 months old) developed mild anaemia and fever [61]. Further, in the most recent study conducted in 2014, the one animal utilized (a pig 6 months of age) exhibited a slight increase in body temperature during the peak of bacteraemia infection (1010 M. parvum cells/mL blood). However, while the packed red cell volume of this animal varied over the course of the study, it only dropped slightly below the low end of the normal reference range at one time point [33]. Experimental infection with M. parvum in negative weaned piglets resulted in clinically apparent disease with severe anaemia in splenectomised animals, whereas non-splenectomised animals remained clinically unremarkable [62]. According to extensive literature research, no further experimental infections with M. parvum have been conducted to date. Therefore, the assumption that this haemoplasma species does not typically cause acute IAP should be interpreted with caution and future studies should consider including more animals and different strains of M. parvum.
During field studies in pigs without obvious clinical deviations, M. parvum was frequently detected with mean bacterial blood loads similar to those found in subclinical M. suis field infections [36,37]. Interestingly, two studies examining the correlation between the presence of haemoplasmas and lower daily weight gains and lower slaughter weights in otherwise healthy fattening pigs, as well as lower numbers of weaned piglets in otherwise healthy sows, identified M. parvum as the dominant species among the diagnosed haemoplasmas [22,34].
Reports of macroscopic or microscopic findings in M. parvum-infected pigs have not been published to date.
3.3. ‘Candidatus Mycoplasma haemosuis’
Like M. suis, ‘Ca. M. haemosuis’ is reported to cause infectious anaemia in pigs, as outlined in two publications [30,35]. Fu et al. mentioned one single piglet showing signs of infectious anaemia associated with a ‘Ca. M. haemosuis’-positive PCR result; however, clinical signs were not described further [30]. Stadler et al. described an acute disease event in fattening pigs caused by ‘Ca. M. haemosuis’. In this case, 30% of a pig herd of 1200 animals showed various clinical signs typically associated with acute IAP. Signs included fever, apathy, pallor, icterus, cyanoses of the ears and legs as well as generalized skin reactions. Figure 2 shows the cutaneous haemorrhages on the ear of one of the diseased pigs [35].

Figure 2.
Cutaneous haemorrhages on the ear and ear base of a pig infected with ‘Candidatus Mycoplasma haemosuis’ [35] (figure owned by the authors, license for re-use is granted by John Wiley and Sons, License Number 5810131448483).
Laboratory investigations further showed normocytic-normochromic anaemia in pigs infected with ‘Ca. M. haemosuis’ having bacterial loads of up to 3.7 × 107 cells/mL blood in the absence of M. suis in the blood of affected pigs [35]. Validation of the pathogenic potential of ‘Ca. M. haemosuis’ via experimental infections are still needed. Postmortem examination was carried out in one of the acutely diseased pigs from the above-mentioned case report by Stadler et al. [35]. Macroscopic and microscopic investigations revealed icterus of the liver and vessels, pallor of mucus membranes, generalized cutaneous haemorrhages, ascites, splenic sinus hyperplasia, follicular hyperplasia and multifocal lymphoplasmacytic dermatitis [35].
Although identified in association with disease, ‘Ca. M. haemosuis’ infections have also been reported in clinically healthy pigs of different age groups [15,30,38]. As with M. suis and M. parvum infections, reported blood bacterial loads in subclinically infected pigs are lower than in those associated with acute disease events [35]. Whether subclinical infections with ‘Ca. M. haemosuis’ have similar production impact as that described for M. suis has yet to be investigated.
4. Pathobiology and Host–Pathogen Interactions
Knowledge of host–pathogen interactions between haemoplasmas and the porcine host is incomplete, and the acquisition of new insights is hampered by the inability to culture porcine haemoplasmas in vitro. Published information on the pathobiology of porcine haemoplasmas and host–pathogen interactions are limited to M. suis, as described in this section.
Pathobiological aspects of M. suis were comprehensively reviewed by Hoelzle et al. in 2014 [2]. In M. suis-infected animals, the cardinal sign of haemolytic anaemia is direct and indirect erythrocyte destruction. Direct ways include erythrocytic destruction induced by cell death, referred to as eryptosis, and extravascular phagocytosis [2]. Both are results of adhesion and invasion of M. suis on and into RBCs [44,63,64,65,66] as well as probable nutrient scavenging [4,48,67,68,69]. Indirect destruction of RBCs can be a result of M. suis-induced auto-reactive IgM and IgG antibodies [70,71,72,73]. At the molecular level, several M. suis proteins have been investigated that appear to be involved in adhesion [65,74,75,76,77]. Interestingly, some of these proteins also function in glucose [65,74]. Table 3 lists these proteins. For MSG1, α-Enolase and OSGEP, the adhesion to erythrocytes has been confirmed in in vitro trials [65,74,75]; However, the function of HspA1 and the seven hypothetical M. suis proteins identified in the study by Dietz et al. as adhesion proteins is only suspected [76,77]. Furthermore, MSG1 and α-Enolase are known to also have enzymatic functions in the degradation of glucose.

Table 3.
M. suis proteins with confirmed or suspected functions as adhesion proteins.
Erythrocyte destruction is clearly associated with the described clinical signs of icteroanaemia. In addition, it is also conceivable that low-grade but persistent erythrocytic destruction and mild anaemia in chronically infected animals can lead to increased susceptibility to respiratory and enteric diseases described for M. suis, as well as to the performance losses described for M. suis and M. parvum.
Apart from interaction and damage to erythrocytes, targeting of endothelial cells resulting in endothelial damage was demonstrated in an in vitro study [57]. Damage to the endothelium likely contributes to the development of coagulation disorders, including disseminated intravascular coagulation (DIC), frequently observed in acute M. suis IAP [3,78]. Additional factors that may lead to coagulopathies include circulating antigen–(auto-) antibody complexes, changes in the erythrocytic membranes or increased eryptosis [3,66]. Alterations in the coagulation system have also been observed during blood transcriptome analyses in an experimental pig model of chronic IAP [79].
In addition to autoantibody erythrocyte destruction, additional immunopathological mechanisms of host immune system modulation are also discussed. During acute IAP in splenectomised pigs, Zachary and Smith were able to observe a suppression in T-lymphocyte blastogenic responses [72]. A more recent study conducted by do Nascimento et al. demonstrated significant alterations in the blood transcriptome of pigs that were chronically infected with M. suis, including alterations in genes associated with immune functions [79]. Downregulation of genes associated with innate immunity, like tlr8, chemokines and chemokine receptors, suggests a general immune suppression in infected pigs [79]. This observation could, in turn, be associated with the described higher susceptibility of M. suis-infected animals to respiratory and enteric diseases and decreased production performance.
5. Epidemiology
5.1. Worldwide Occurrence
A literature search revealed evidence of the occurrence of porcine haemoplasmas in domestic pigs on all the continents. Most of the published data are based on individual case reports rather than on prevalence studies. Table 4 provides an overview of the available literature, describing the occurrence of porcine haemoplasmas in domestic pigs in different countries. It should be mentioned that most of the reports do not include a valid differentiation between the different haemoplasma species. M. parvum was definitively identified in only a couple of cases [15,22,27,29,30,33,34,36,39,60,61,62,80,81,82,83] and the novel ‘Ca. M. haemosuis’ has so far only been described in China, Korea, Thailand and Germany [15,30,35,38,82].

Table 4.
Reports describing the occurrence of porcine haemoplasmas worldwide.
Besides their occurrence in domesticated pigs, M. suis and M. parvum have been detected in wild boars in Brazil (both haemoplasma species) and Germany (M. suis only) [116,117,118,119]. M. suis has also been described in white-lipped peccaries (Tayassu pecar) in Brazil [118].
5.2. Prevalence
Table 5 provides a summary of prevalence data from published studies that used molecular diagnostics to specifically identify the presence of the three known porcine haemoplasma species in domestic pigs. Only studies that sampled animals from more than one farm are included in this summary.

Table 5.
Published prevalence data for M. suis, M. parvum and ‘Ca. M. haemosuis’.
None of the listed publications reported clinical signs in animals included in these prevalence studies. Instead, the majority either claim the sampling of healthy animals, or no information is given on the clinical status of animals, giving the impression that obvious clinical signs of haemoplasma-related disease were not present at the time of sample collection. Summarizing the presented data, the three porcine haemoplasma species seem to be widely distributed, with prevalences of up to 72.2%. Comparative analyses of the prevalences of the different haemoplasma species are difficult to obtain from the data presented. The overall prevalence of M. suis appears to be higher than those of M. parvum and ‘Ca. M. haemosuis’; however, more data were collected for M. suis, which can lead to a distorted representation. Only two out of the cited studies, one from Korea [82] and one from Germany [37], allow a direct comparison of the three porcine haemoplasma species in the same samples. In both studies, M. parvum was detected more frequently than M. suis and ‘Ca. M. haemosuis’. Similarly, the study by Watanabe et al., which detected M. suis and M. parvum, describes more frequent detection of M. parvum compared to M. suis [36]. A possible explanation could be the lower virulence of M. parvum compared to M. suis and ‘Ca. M. haemosuis’, which may allow M. parvum to circulate undetected in the pig population for a longer time, providing more opportunity to spread between animals. Further studies are needed to confirm the predominance of M. parvum compared to M. suis and ‘Ca. M. haemosuis’ in the field. Regarding the different age groups, prevalences in fattening pigs seem to be more similar than in sows. Any interpretation regarding piglets and boars is not meaningful due to the different quantities of available data. The same is true for comparisons between regions or continents. Further trials should not only focus on the comparison of the different haemoplasma species but should also enable profound comparisons between age groups and geographic regions.
5.3. Transmission Routes
In general, haemoplasmas are known to be blood-transmitted bacteria. In the case of pigs, this can include ranking fights in groups iatrogenic transmission through reusing needles and zootechnical measures (i.e., castration, tail docking) [120]. Transmission of porcine haemoplasmas through blood-sucking arthropods has been proven in a few cases in the literature. In detail, Seamer verified the successful transmission of M. parvum via the pig louse (Haematopinus suis), Prullage described the successful transmission of M. suis via the stable fly (Stomoxys calcitrans) and the yellow fever mosquito (Aedes aegypti) under experimental conditions [62,121]. Further, M. suis and M. parvum have been detected in different arthropods in the field, like the pig louse (Haematopinus suis)and the stable fly (Stomoxys calcitrans) as well as in two different tick species (Ambylomma sculptum and Ambylomma ovale) [93,102,117].
Among the porcine haemoplasma species, studies on transmission routes have mainly been conducted with M. suis rather than with M. parvum and ‘Ca. M. haemosuis’. In experimental infections, M. suis and M. parvum are usually successfully transmitted via parenteral inoculation of M. suis/M. parvum-containing blood [3,33,40]. Oral transmission with M. suis-containing blood was successful using an inoculum with a very high bacterial load but unsuccessful with a lower-concentration inoculum representing quantities of M. suis that are typically found in field infections [120,122]. Therefore, oral transmission of M. suis-containing blood does not seem to play a role in field conditions [122].
Transmission of M. suis via artificial insemination of blood-contaminated semen to sows has also been described in the literature [123].
In addition to horizontal transmission, vertical transmission of M. suis and ‘Ca. M. haemosuis’ from sows to their offspring has been described [20,38,42,124].
Blood-independent shedding of M. suis has been demonstrated under experimental conditions, where M. suis DNA was detected in saliva, urine as well as in nasal and vaginal secretions during acute disease events of infectious anaemia [125].
On the contrary, another study failed to show the presence of M. suis and ‘Ca. M. haemosuis’ in urine, saliva and semen samples of naturally infected pigs in the field [122]. The authors therefore attribute a minor role to blood-independent transmission of porcine haemoplasmas [122].
6. Diagnostics
6.1. Cultivation
Any attempts to cultivate porcine haemoplasmas in vitro have failed so far and animal trials remain the only possible means of replicating these bacteria. Cultivation trials using M. suis resulted in the maintenance of bacterial numbers and transformation of bacterial cells to nanoforms but failed to replicate the organisms [6,69]. Those trials were conducted in porcine erythrocyte cultures [69] and in cell-free Mycoplasma media [6]. An obvious explanation for the unsuccessful cultivation attempts is the use of non-optimal media conditions. Haemoplasmas seem to be highly specialized and adapted to an environment that has not yet been sufficiently replicated [2].
6.2. Microscopy
Due to the inability to cultivate porcine haemoplasmas, microscopic examination of blood smears was the standard method for diagnosing haemoplasmosis in the pre-PCR era. Light microscopy with Romanowsky staining methods like Giemsa or Wright has been used traditionally [63,105,126]. Depending on the stain type and pH, haemoplasmas appear as individual or clustered pale red to reddish-purple dots on the surface of erythrocytes or free in the plasma [59,63,64,105,126]. Figure 3 shows a Giemsa-stained blood smear of a pig infected with ‘Ca. M. haemosuis’.
Figure 3.
Giemsa-stained blood smear of a pig infected with ‘Ca. M. haemosuis’. ‘Ca. M. haemosuis’ cells occur as small purple dots on the red blood cells (indicated by arrows) [30] (published open access under the terms of the Creative Commons Attribution Non-Commercial No Derivatives (by-nc-nd) License: CC-BY-NC-ND 4.0: https://creativecommons.org/licenses/by-nc-nd/4.0/).
Additionally, fluorescence microscopy with acridine orange-stained blood smears was often used to detect M. suis, where the bacterial cells appear as light-orange dots with a yellow-green undertone [50,51]. An example of an acridine orange-stained blood smear from a pig infected with M. suis is shown in Figure 4 [50].
Figure 4.
Acridine orange-stained blood smear of M. suis-infected pigs. M. suis cells are abundant and the staining of their DNA makes them appear as orange dots on the erythrocyte surface [50] (figure owned by the authors, license for re-use is granted by Elsevier, License number 5819149239986).
Microscopic methods have some disadvantages when it comes to sensitivity and specificity [51,105]. Dying artefacts as well as Howell–Jolly bodies can easily be confused with bacteria and, thus, can lead to a misinterpretation of examination results [127]. Moreover, microscopic detection only seems to be reliable with a certain bacterial load [51]. Since chronically infected animals usually have lower bacterial blood loads, false negative results can easily occur [51]. Furthermore, microscopy is not suitable for species differentiation of the porcine haemoplasmas.
6.3. Molecular Methods
Molecular detection methods are now commonly used for direct pathogen detection. Various conventional and real-time PCR protocols targeting different genes have been published and used for the detection of M. suis, M. parvum and ‘Ca. M. haemosuis’ in porcine blood samples. While most of the protocols are cross-specific for the haemoplasma species, others allow precise differentiation of the three porcine haemoplasma species without subsequent sequencing [19,36,37,38,82,100,127]. Table 6 provides an overview of published PCR protocols used for porcine haemoplasmas that allow species differentiation without further amplicon sequencing.

Table 6.
PCR protocols that allow differentiation of the porcine haemoplasmas species.
Apart from PCR protocols, single protocols for other molecular methods for direct pathogen detection, e.g., loop-mediated isothermal amplification (LAMP) or in situ hybridization, have been published [127,128].
6.4. Serological Methods
Protocols for the detection of antibodies against M. suis, but not for the detection of antibodies against M. parvum or ‘Ca. M. haemosuis’, have been described in the literature. However, according to available publications, serological methods do not seem to be used commonly in the diagnosis of M. suis infections in the field. The development and use of meaningful test systems require the availability of suitable test antigens. However, antigen availability is strongly limited due to the lack of in vitro cultivation. Antigens purified from the blood of M. suis-infected pigs have been used in enzyme-linked-immunosorbent assays (ELISAs), but their use is accompanied by some disadvantages, like standardization limitations, high variability in antigen structure and low availability due to the need for animal sampling [129,130,131]. Two recombinant M. suis antigens have been described and used in routine diagnostics in ELISAs [132,133]. For standard use of antibody detection to diagnose haemoplasma in pigs, the role of antibodies in IAP should be better investigated. In addition, possible cross-reactions with other haemoplasma species and non-haemotrophic mycoplasma in pigs should be thoroughly investigated. Only then can the suitability of antibody detection be assessed for practical use.
7. Prevention and Treatment
With a lack of commercial vaccines, no pathogen-specific preventive measures against porcine haemoplasmas are currently available. So far, only two vaccination trials for M. suis have been published. Whereas one experiment was able to induce an immunological response resembling partial protection against M. suis in piglets [134], another experiment demonstrated an exacerbation of clinical signs in vaccinated pigs after the challenge [135].
Considering the blood-dependent transmission route of haemoplasmas, combating biting and blood-sucking arthropods and one-use needle practices can help reduce transmission [133].
For all three porcine haemoplasma species, antibiotic treatment using tetracyclines has been considered successful in many cases to improve the clinical condition of infected animals as well as to reduce the number of bacteria in the blood [35,40,47,62,108]. Complete elimination of haemoplasmas through antibiotic treatment, however, was not achieved in all the cases [3]. On the contrary, antibiotic treatment was unsuccessful in the case of acute IAP induced by experimental infection in the study by Groebel et al. [44]. The use of antibiotics against subclinical and chronic infections, as they are commonly found in the field, has not yet been discussed. This represents a major knowledge gap for practitioners when supervising affected farms. As a supportive measure, oral administration of glucose helped to counteract hypoglycaemia during acute infectious anaemia caused by M. suis [40].
8. Conclusions
This review provides an overview of current knowledge on the three porcine haemoplasma species M. suis, M. parvum and ‘Ca. M. haemosuis’. This review also highlights gaps in our current knowledge, such as mechanisms of host–pathogen interactions and the significance of subclinical infections in naturally infected pigs. This evaluation of existing studies also illustrates the limited availability of data on ‘Ca. M. haemosuis and M. parvum compared with M. suis. Increasing our knowledge and understanding of all three porcine haemoplasmas may assist practitioners with recognizing haemoplasma-associated disease, interpreting diagnostic results and guiding clinically relevant decisions in prevention and treatment.
Author Contributions
Writing—original draft preparation, J.A., M.E. and J.S.; writing—review and editing, K.H., M.R. and L.E.H. All authors have read and agreed to the published version of the manuscript.
Funding
This research received no external funding.
Data Availability Statement
Not applicable.
Conflicts of Interest
The authors declare no conflicts of interest.
References
- Messick, J.B. Hemotrophic mycoplasmas (hemoplasmas): A review and new insights into pathogenic potential. Vet. Clin. Pathol. 2004, 33, 2–13. [Google Scholar] [CrossRef] [PubMed]
- Hoelzle, L.E.; Zeder, M.; Felder, K.M.; Hoelzle, K. Pathobiology of Mycoplasma suis. Vet. J. 2014, 202, 20–25. [Google Scholar] [CrossRef] [PubMed]
- Stadler, J.; Ade, J.; Hermanns, W.; Ritzmann, M.; Wentzel, S.; Hoelzle, K.; Hoelzle, L.E. Clinical, haematological and pathomorphological findings in Mycoplasma suis infected pigs. BMC Vet. Res. 2021, 17, 214. [Google Scholar] [CrossRef] [PubMed]
- Guimaraes, A.M.; Santos, A.P.; SanMiguel, P.; Walter, T.; Timenetsky, J.; Messick, J.B. Complete genome sequence of Mycoplasma suis and insights into its biology and adaption to an erythrocyte niche. PLoS ONE 2011, 6, e19574. [Google Scholar] [CrossRef] [PubMed]
- Schilling, V. Eperythrozoon coccoides, eine neue durch Splenektomie aktivierbare Dauerinfektion der weissen Maus. Klin. Wochenschr. 1928, 7, 1853–1855. [Google Scholar] [CrossRef]
- Schreiner, S.A.; Hoelzle, K.; Hofmann-Lehmann, R.; Hamburger, A.; Wittenbrink, M.M.; Kramer, M.M.; Sokoli, A.; Felder, K.M.; Groebel, K.; Hoelzle, L.E. Nanotransformation of the haemotrophic Mycoplasma suis during in vitro cultivation attempts using modified cell free Mycoplasma media. Vet. Microbiol. 2012, 160, 227–232. [Google Scholar] [CrossRef] [PubMed][Green Version]
- Millán, J.; Di Cataldo, S.; Volokhov, D.V.; Becker, D.J. Worldwide occurrence of haemoplasmas in wildlife: Insights into the patterns of infection, transmission, pathology and zoonotic potential. Transbound. Emerg. Dis. 2021, 68, 3236–3256. [Google Scholar] [CrossRef] [PubMed]
- Rikihisa, Y.; Kawahara, M.; Wen, B.; Kociba, G.; Fuerst, P.; Kawamori, F.; Suto, C.; Shibata, S.; Futohashi, M. Western immunoblot analysis of Haemobartonella muris and comparison of 16S rRNA gene sequences of H. muris, H. felis, and Eperythrozoon suis. J. Clin. Microbiol. 1997, 35, 823–829. [Google Scholar] [CrossRef] [PubMed]
- Neimark, H.; Johansson, K.E.; Rikihisa, Y.; Tully, J.G. Proposal to transfer some members of the genera Haemobartonella and Eperythrozoon to the genus Mycoplasma with descriptions of ‘Candidatus Mycoplasma haemofelis’, ‘Candidatus Mycoplasma haemomuris’, ‘Candidatus Mycoplasma haemosuis’ and ‘Candidatus Mycoplasma wenyonii’. Int. J. Syst. Evol. Microbiol. 2001, 51, 891–899. [Google Scholar] [CrossRef]
- Neimark, H.; Johansson, K.E.; Rikihisa, Y.; Tully, J.G. Revision of haemotrophic Mycoplasma species names. Int. J. Syst. Evol. Microbiol. 2002, 52, 683. [Google Scholar] [CrossRef]
- Messick, J.B.; Walker, P.G.; Raphael, W.; Berent, L.; Shi, X. ‘Candidatus mycoplasma haemodidelphidis’ sp. nov., ‘Candidatus mycoplasma haemolamae’ sp. nov. and Mycoplasma haemocanis comb. nov., haemotrophic parasites from a naturally infected opossum (Didelphis virginiana), alpaca (Lama pacos) and dog (Canis familiaris): Phylogenetic and secondary structural relatedness of their 16S rRNA genes to other mycoplasmas. Int. J. Syst. Evol. Microbiol. 2002, 52, 693–698. [Google Scholar] [CrossRef] [PubMed]
- Tasker, S.; Helps, C.R.; Day, M.J.; Harbour, D.A.; Shaw, S.E.; Harrus, S.; Baneth, G.; Lobetti, R.G.; Malik, R.; Beaufils, J.P.; et al. Phylogenetic analysis of hemoplasma species: An international study. J. Clin. Microbiol. 2003, 41, 3877–3880. [Google Scholar] [CrossRef]
- Peters, I.R.; Helps, C.R.; McAuliffe, L.; Neimark, H.; Lappin, M.R.; Gruffydd-Jones, T.J.; Day, M.J.; Hoelzle, L.E.; Willi, B.; Meli, M.; et al. RNase P RNA gene (rnpB) phylogeny of Hemoplasmas and other Mycoplasma species. J. Clin. Microbiol. 2008, 46, 1873–1877. [Google Scholar] [CrossRef] [PubMed]
- Watanabe, Y.; Fujihara, M.; Obara, H.; Nagai, K.; Harasawa, R. Two genetic clusters in swine hemoplasmas revealed by analyses of the 16S rRNA and RNase P RNA genes. J. Vet. Med. Sci. 2011, 73, 1657–1661. [Google Scholar] [CrossRef]
- Thongmeesee, K.; Kamkong, P.; Thanee, S.; Wattanapansak, S.; Kaewthamasorn, M.; Tiawsirisup, S. Molecular detection and genetic analysis of porcine haemoplasmas in commercial pig farms from Thailand reveal a putative novel species. Transbound. Emerg. Dis. 2022, 69, e2028–e2040. [Google Scholar] [CrossRef]
- Zhou, R.Q.; Nie, K.; Huang, H.C.; Hu, S.J.; Zhou, Z.Y.; Luo, H.L. Phylogenetic analysis of Mycoplasma suis isolates based on 16S rRNA gene sequence in China. Vet. Res. Commun. 2009, 33, 855–863. [Google Scholar] [CrossRef]
- Gupta, R.S.; Sawnani, S.; Adeolu, M.; Alnajar, S.; Oren, A. Phylogenetic framework for the phylum Tenericutes based on genome sequence data: Proposal for the creation of a new order Mycoplasmoidales ord. nov., containing two new families Mycoplasmoidaceae fam. nov. and Metamycoplasmataceae fam. nov. harbouring Eperythrozoon, Ureaplasma and five novel genera. Antonie Van Leeuwenhoek 2018, 111, 1583–1630. [Google Scholar] [CrossRef]
- Guimaraes, A.M.; Santos, A.P.; do Nascimento, N.C.; Timenetsky, J.; Messick, J.B. Comparative genomics and phylogenomics of hemotrophic mycoplasmas. PLoS ONE 2014, 9, e91445. [Google Scholar] [CrossRef] [PubMed]
- Hoelzle, L.E. Significance of haemotrophic mycoplasmas in veterinary medicine with particular regard to the Mycoplasma suis infection in swine. Berl. Munch. Tierarztl. Wochenschr. 2007, 120, 34–41. [Google Scholar]
- Stadler, J.; Willi, S.; Ritzmann, M.; Eddicks, M.; Ade, J.; Hoelzle, K.; Hoelzle, L.E. Detection of Mycoplasma suis in pre-suckling piglets indicates a vertical transmission. BMC Vet. Res. 2019, 15, 252. [Google Scholar] [CrossRef]
- Brissonnier, M.; Normand, V.; Lebret, A.; Moalic, P.Y.; Guyomard, A.S.; Bachy, V.; Berton, P.; Auvigne, V.; Bouchet, F.; Boulbria, G. Frequency of infection with Mycoplasma suis in gestating sows using qPCR on ten commercial French herds, and impact of the infection on clinical, haematological and biochemical parameters. Porc. Health Manag. 2020, 6, 13. [Google Scholar] [CrossRef] [PubMed]
- Petri, F.A.M.; Sonalio, K.; de Souza Almeida, H.M.; Ferraz, M.E.S.; Storino, G.Y.; de Souza, M.R.; André, M.R.; de Oliveira, L.G. Porcine hemothropic mycoplasmas infection associated with productive impact in intensive pig production. Porc. Health Manag. 2020, 6, 33. [Google Scholar] [CrossRef] [PubMed]
- Henry, S.C. Clinical observations on eperythrozoonosis. J. Am. Vet. Med. Assoc. 1979, 174, 601–603. [Google Scholar] [PubMed]
- Zinn, G.M.; Jesse, G.W.; Dobson, A.W. Effect of eperythrozoonosis on sow productivity. J. Am. Vet. Med. Assoc. 1983, 182, 369–371. [Google Scholar] [PubMed]
- Doyle, L.P. A Rickettsia-like or anaplasmosis-like disease in swine. J. Am. Vet. Med. Assoc. 1932, 81, 668–671. [Google Scholar]
- Kinsley, A. Protozoan-like body in the blood of swine. Vet. Med. 1932, 27, 196. [Google Scholar]
- Splitter, E.J. Eperythrozoon suis n. sp. and Eperythrozoon parvum n. sp., 2 new blood parasites of swine. Science 1950, 111, 513–514. [Google Scholar] [CrossRef]
- Splitter, E.J. Eperythrozoon suis, the etiologic agent of ictero-anemia or an anaplasmosis-like disease in swine. Am. J. Vet. Res. 1950, 11, 324–330. [Google Scholar]
- do Nascimento, N.C.; Dos Santos, A.P.; Chu, Y.; Guimaraes, A.M.; Pagliaro, A.; Messick, J.B. Genome Sequence of Mycoplasma parvum (Formerly Eperythrozoon parvum), a Diminutive Hemoplasma of the Pig. Genome Announc. 2013, 1, e00986-13. [Google Scholar] [CrossRef]
- Fu, Y.; Shi, T.; Xu, L.; Wei, W.; Lu, F.; Zhang, X.; Yuan, X.; Li, J.; Lv, J.; Fang, W. Identification of a novel Hemoplasma species from pigs in Zhejiang province, China. J. Vet. Med. Sci. 2017, 79, 864–870. [Google Scholar] [CrossRef]
- Messick, J.B.; Santos, A.P.; Guimaraes, A.M. Complete genome sequences of two hemotropic mycoplasmas, Mycoplasma haemofelis strain Ohio2 and Mycoplasma suis Strain Illinois. J. Bacteriol. 2011, 193, 2068–2069. [Google Scholar] [CrossRef] [PubMed]
- Oehlerking, J.; Kube, M.; Felder, K.M.; Matter, D.; Wittenbrink, M.M.; Schwarzenbach, S.; Kramer, M.M.; Hoelzle, K.; Hoelzle, L.E. Complete genome sequence of the hemotrophic Mycoplasma suis strain KI3806. J. Bacteriol. 2011, 193, 2369–2370. [Google Scholar] [CrossRef] [PubMed]
- do Nascimento, N.C.; dos Santos, A.P.; Chu, Y.; Guimaraes, A.M.; Baird, A.N.; Weil, A.B.; Messick, J.B. Microscopy and genomic analysis of Mycoplasma parvum strain Indiana. Vet. Res. 2014, 45, 86. [Google Scholar] [CrossRef] [PubMed]
- Sonalio, K.; Perles, L.; Gatto, I.R.H.; do Amaral, R.B.; Almeida, H.M.; Galdeano, J.V.B.; Vieira, R.F.; Andre, M.R.; de Oliveira, L.G. Genetic diversity of emerging hemotropic mycoplasmas in domestic pigs from Brazil. Transbound. Emerg. Dis. 2021, 68, 1162–1174. [Google Scholar] [CrossRef] [PubMed]
- Stadler, J.; Ade, J.; Ritzmann, M.; Hoelzle, K.; Hoelzle, L.E. Detection of a novel haemoplasma species in fattening pigs with skin alterations, fever and anaemia. Vet. Rec. 2020, 187, 66. [Google Scholar] [CrossRef] [PubMed]
- Watanabe, Y.; Fujihara, M.; Suzuki, J.; Sasaoka, F.; Nagai, K.; Harasawa, R. Prevalence of swine hemoplasmas revealed by real-time PCR using 16S rRNA gene primers. J. Vet. Med. Sci. 2012, 74, 1315–1318. [Google Scholar] [CrossRef] [PubMed][Green Version]
- Ade, J.; Hoelzle, K.; Stadler, J.; Ritzmann, M.; Hoelzle, L.E. Occurrence of Mycoplasma parvum in German Pigs of Different Age Groups Using a Novel Quantitative Real-Time PCR Assay. Pathogens 2022, 11, 1374. [Google Scholar] [CrossRef] [PubMed]
- Ade, J.; Stadler, J.; Ritzmann, M.; Zübert, C.; Hoelzle, K.; Hoelzle, L.E. Occurrence of ‘Candidatus Mycoplasma haemosuis’ in fattening pigs, sows and piglets in Germany using a novel gap-based quantitative real-time PCR assay. BMC Vet. Res. 2022, 18, 40. [Google Scholar] [CrossRef] [PubMed]
- Dipeolu, O.O.; Majaro, O.M.; Akinboade, O.A.; Nwufor, K.J. Studies on the blood parasites of pigs in Ibadan, Nigeria. Vet. Parasitol. 1982, 10, 87–90. [Google Scholar] [CrossRef]
- Stadler, J.; Jannasch, C.; Mack, S.L.; Dietz, S.; Zöls, S.; Ritzmann, M.; Hoelzle, K.; Hoelzle, L.E. Clinical and haematological characterisation of Mycoplasma suis infections in splenectomised and non-splenectomised pigs. Vet. Microbiol. 2014, 172, 294–300. [Google Scholar] [CrossRef]
- Splitter, E.J. Icteroanemia in swine. Vet. Med. 1951, 46, 14–15. [Google Scholar] [PubMed]
- Preston, K.; Greve, J. Eperythrozoonosis in 4-week-old pigs. Iowa State Univ. Vet. 1965, 27, 119 passim. [Google Scholar] [PubMed]
- Henderson, J.; O’hagan, J.; Hawe, S.; Pratt, M. Anaemia and low viability in piglets infected with Eperythrozoon suis. Vet. Rec. 1997, 140, 144–146. [Google Scholar] [CrossRef] [PubMed]
- Groebel, K.; Hoelzle, K.; Wittenbrink, M.; Ziegler, U.; Hoelzle, L. Mycoplasma suis invades porcine erythrocytes. Infect. Immun. 2009, 77, 576–584. [Google Scholar] [CrossRef] [PubMed]
- Heinritzi, K. Haematologie und Metabolismus des eperythrozoonotischen Anfalls. Prakt. Tierarzt 1984, 65, 40–44. [Google Scholar]
- Strait, E.L.; Hawkins, P.A.; Wilson, W.D. Dysgalactia associated with Mycoplasma suis infection in a sow herd. J. Am. Vet. Med. Assoc. 2012, 241, 1666–1667. [Google Scholar] [CrossRef] [PubMed]
- Heinritzi, K.; Wentz, I.; Bollwahn, W. Hematological findings in acute eperythrozoonosis of swine. Berl. Und Muenchener Tieraerztliche Wochenschr. 1984, 97, 404–407. [Google Scholar]
- Heinritzi, K.; Plank, G.; Peteranderl, W.; Sandner, N. Untersuchungen zum Säure-Basen-Haushalt und Kohlenhydratstoffwechsel bei der Infektion mit Eperythrozoon suis. J. Vet. Med. Ser. B 1990, 37, 412–417. [Google Scholar] [CrossRef]
- Bollwahn, W. Die eperythrozoonose (İkteroanämie) der Schweine. Prakt. Tierarzt 1982, 63, 1043–1046. [Google Scholar]
- Hoelzle, L.E. Haemotrophic mycoplasmas: Recent advances in Mycoplasma suis. Vet. Microbiol. 2008, 130, 215–226. [Google Scholar] [CrossRef]
- Ritzmann, M.; Grimm, J.; Heinritzi, K.; Hoelzle, K.; Hoelzle, L.E. Prevalence of Mycoplasma suis in slaughter pigs, with correlation of PCR results to hematological findings. Vet. Microbiol. 2009, 133, 84–91. [Google Scholar] [CrossRef] [PubMed]
- Oberst, R.D.; Gwaltney, S.M.; Hays, M.P.; Morgan, S.; Stair, E.L. Experimental infections and natural outbreaks of eperythrozoonosis in pigs identified by PCR-DNA hybridizations. J. Vet. Diagn. Investig. 1993, 5, 351–358. [Google Scholar] [CrossRef] [PubMed]
- Gwaltney, S.M.; Oberst, R.D. Comparison of an improved polymerase chain reaction protocol and the indirect hemagglutination assay in the detection of Eperythrozoon suis infection. J. Vet. Diagn. Investig. 1994, 6, 321–325. [Google Scholar] [CrossRef] [PubMed]
- Pereyra, N.; Sarradell, J.; Cane, F.; Francois, S.; Pidone, C.; Comba, E.; Rodríguez, F.; Guglielmone, A. Detección de Mycoplasma suis en casos clínicos de síndrome del desmedro multisistémico posdestete en porcinos. Rev. Argent. De Microbiol. 2006, 38, 130–133. [Google Scholar]
- Dent, B.T.; Stevens, K.A.; Korvick, D.L.; Clymer, J.W. Mycoplasma suis infection in pigs after splenectomy. Lab Anim. 2013, 42, 125–128. [Google Scholar] [CrossRef] [PubMed]
- Tseng, C.; Wang, J. Pathological features of experimental infection with Eperythrozoon suis in pigs. Taiwan J. Vet. Med. Anim. Husb. 1991, 58, 27–32. [Google Scholar]
- Sokoli, A.; Groebel, K.; Hoelzle, K.; Amselgruber, W.M.; Mateos, J.M.; Schneider, M.K.; Ziegler, U.; Felder, K.M.; Hoelzle, L.E. Mycoplasma suis infection results endothelial cell damage and activation: New insight into the cell tropism and pathogenicity of hemotrophic mycoplasma. Vet. Res. 2013, 44, 1–12. [Google Scholar] [CrossRef] [PubMed]
- Quin, A. A discussion of some diseases of swine. Can. Vet. J. 1960, 1, 246. [Google Scholar] [PubMed]
- Pospischil, A.; Hoffmann, R. Eperythrozoon suis in naturally infected pigs: A light and electron microscopic study. Vet. Pathol. 1982, 19, 651–657. [Google Scholar] [CrossRef]
- Jansen, B. The occurrence of Eperythrozoon parvum Splitter, 1950 in South African swine. Onderstepoort J. Vet. Res. 1952, 25, 6. [Google Scholar]
- Jennings, A.; Seamer, J. A new blood parasite in British pigs. Nature 1956, 178, 153–154. [Google Scholar] [CrossRef]
- Seamer, J. Studies with Eperythrozoon parvum Splitter, 1950. Parasitology 1960, 50, 67–80. [Google Scholar] [CrossRef] [PubMed]
- Zachary, J.; Basgall, E. Erythrocyte membrane alterations associated with the attachment and replication of Eperythrozoon suis: A light and electron microscopic study. Vet. Pathol. 1985, 22, 164–170. [Google Scholar] [CrossRef] [PubMed]
- Liebich, H.; Heinritzi, K. Licht-und elektronenmikroskopische Untersuchungen an Eperythrozoon suis Tierärztl. Prax 1992, 20, 270–274. [Google Scholar]
- Hoelzle, L.E.; Hoelzle, K.; Helbling, M.; Aupperle, H.; Schoon, H.A.; Ritzmann, M.; Heinritzi, K.; Felder, K.M.; Wittenbrink, M.M. MSG1, a surface-localised protein of Mycoplasma suis is involved in the adhesion to erythrocytes. Microbes Infect. 2007, 9, 466–474. [Google Scholar] [CrossRef]
- Felder, K.M.; Hoelzle, K.; Ritzmann, M.; Kilchling, T.; Schiele, D.; Heinritzi, K.; Groebel, K.; Hoelzle, L.E. Hemotrophic mycoplasmas induce programmed cell death in red blood cells. Cell. Physiol. Biochem. 2011, 27, 557–564. [Google Scholar] [CrossRef]
- Heinritzi, K.; Peteranderl, W.; Plank, G. Eperythrozoon-infektion beim schwein: Einfluss auf säure-basen-haushalt sowie glucose-, lactat-und pyruvatgehalt des venösen blutes. Dtsch. Tierärztliche Wochenschr. 1990, 97, 31–34. [Google Scholar]
- Smith, J.; Cipriano, J.; Hall, S. In Vitro and in vivo glucose consumption in swine eperythrozoonosis. J. Vet. Med. Ser. B 1990, 37, 587–592. [Google Scholar] [CrossRef] [PubMed]
- Nonaka, N.; Thacker, B.; van Veen, T.S.; Bull, R. In Vitro maintenance of Eperythrozoon suis. Vet. Parasitol. 1996, 61, 181–199. [Google Scholar] [CrossRef]
- Juengling, A.; Erhard, M.; Heinritzi, K. Bedeutung und Verlauf eines Kalteagglutinins beider Eperythrozoon suis-Infektion des Schweines. Berl. Muench. Tieraerztl. Wochenschr. 1994, 107, 271–275. [Google Scholar]
- Felder, K.M.; Hoelzle, K.; Heinritzi, K.; Ritzmann, M.; Hoelzle, L.E. Antibodies to actin in autoimmune haemolytic anaemia. BMC Vet. Res. 2010, 6, 1–9. [Google Scholar] [CrossRef] [PubMed]
- Zachary, J.; Smith, A. Experimental porcine eperythrozoonosis: T-lymphocyte suppression and misdirected immune responses. Am. J. Vet. Res. 1985, 46, 821–830. [Google Scholar] [PubMed]
- Hoffmann, R.; Schmid, D.; Hoffmann-Fezer, G. Erythrocyte antibodies in porcine eperythrozoonosis. Vet. Immunol. Immunopathol. 1981, 2, 111–119. [Google Scholar] [CrossRef] [PubMed]
- Schreiner, S.A.; Sokoli, A.; Felder, K.M.; Wittenbrink, M.M.; Schwarzenbach, S.; Guhl, B.; Hoelzle, K.; Hoelzle, L.E. The surface-localised α-enolase of Mycoplasma suis is an adhesion protein. Vet. Microbiol. 2012, 156, 88–95. [Google Scholar] [CrossRef] [PubMed]
- Song, Q.; Song, W.; Zhang, W.; He, L.; Fang, R.; Zhou, Y.; Shen, B.; Hu, M.; Zhao, J. Identification of erythrocyte membrane proteins interacting with Mycoplasma suis GAPDH and OSGEP. Res. Vet. Sci. 2018, 119, 85–90. [Google Scholar] [CrossRef] [PubMed]
- Dietz, S.; Lassek, C.; Mack, S.L.; Ritzmann, M.; Stadler, J.; Becher, D.; Hoelzle, K.; Riedel, K.; Hoelzle, L.E. Updating the proteome of the uncultivable hemotrophic Mycoplasma suis in experimentally infected pigs. Proteomics 2016, 16, 609–613. [Google Scholar] [CrossRef]
- Hoelzle, L.E.; Hoelzle, K.; Harder, A.; Ritzmann, M.; Aupperle, H.; Schoon, H.A.; Heinritzi, K.; Wittenbrink, M.M. First identification and functional characterization of an immunogenic protein in unculturable haemotrophic Mycoplasmas (Mycoplasma suis HspA1). FEMS Immunol. Med. Microbiol. 2007, 49, 215–223. [Google Scholar] [CrossRef]
- Plank, G.; Heinritzi, K. Disseminated intravascular coagulation in eperythrozoonosis of swine. Berl. und Muench. Tieraerztl. Wochenschr. 1990, 103, 13–18. [Google Scholar]
- do Nascimento, N.C.; Guimaraes, A.M.S.; Dos Santos, A.P.; Chu, Y.; Marques, L.M.; Messick, J.B. RNA-Seq based transcriptome of whole blood from immunocompetent pigs (Sus scrofa) experimentally infected with Mycoplasma suis strain Illinois. Vet. Res. 2018, 49, 49. [Google Scholar] [CrossRef]
- Uilenberg, G.; Zeeuwen, A.; de Ruijter, T. Eperythrozoon parvum (Rickettsiales) in swine in the Netherland. Tijdschr. Voor Diergeneeskd. 1981, 106, 456. [Google Scholar]
- Gatto, I.R.H.; Sonálio, K.; Amaral, R.B.D.; Morés, N.; Dalla Costa, O.A.; André, M.R.; de Oliveira, L.G. High frequency and molecular characterization of porcine hemotrophic mycoplasmas in Brazil. Vet. Microbiol. 2019, 231, 33–39. [Google Scholar] [CrossRef] [PubMed]
- Seo, M.G.; Kwon, O.D.; Kwak, D. Prevalence and phylogenetic analysis of hemoplasma species in domestic pigs in Korea. Parasit. Vectors 2019, 12, 378. [Google Scholar] [CrossRef] [PubMed]
- Barnett, S. Eperythrozoon parvum in pigs in Kenya. Bull. Epizoot. Dis. Afr. 1963, 11, 185–195. [Google Scholar] [PubMed]
- Wu, J.; Yu, J.; Song, C.; Sun, S.; Wang, Z. Porcine eperythrozoonosis in China. Ann. N. Y. Acad. Sci. 2006, 1081, 280–285. [Google Scholar] [CrossRef] [PubMed]
- Yuan, C.L.; Liang, A.B.; Yao, C.B.; Yang, Z.B.; Zhu, J.G.; Cui, L.; Yu, F.; Zhu, N.Y.; Yang, X.W.; Hua, X.G. Prevalence of Mycoplasma suis (Eperythrozoon suis) infection in swine and swine-farm workers in Shanghai, China. Am. J. Vet. Res. 2009, 70, 890–894. [Google Scholar] [CrossRef] [PubMed]
- Song, Q.; Wang, L.; Fang, R.; Khan, M.K.; Zhou, Y.; Zhao, J. Detection of Mycoplasma wenyonii in cattle and transmission vectors by the loop-mediated isothermal amplification (LAMP) assay. Trop. Anim. Health Prod. 2013, 45, 247–250. [Google Scholar] [CrossRef] [PubMed]
- Zhongyang, L.; Jiansong, Z.; Yijuan, S.; Yuting, X.; Yufeng, L.; Jiarong, X. Seroprevalence of Mycoplasma suis infection in pigs in eastern China as estimated by a blocking enzyme-linked immunosorbent assay. Can. J. Vet. Res. 2017, 81, 313–317. [Google Scholar] [PubMed]
- Jeon, Y. Morphological study and experimental production of porcine eperythrozoonosis. Res. Rep. Off. Rural. Dev. Korea Vet. Ser. 1971, 14, 35–40. [Google Scholar]
- Assoku, R.K.G. A study of the incidence of blood-borne parasites of livestock in southern Ghana. Bull. Anim. Health Prod. Afr. 1979, 271, 29–39. [Google Scholar]
- Okon, E.D. Blood parasites of local pigs in Ibadan. Trop. Anim. Health Prod. 1976, 8, 87–90. [Google Scholar] [CrossRef]
- Dipeolu, O.O.; Otesile, E.B.; Fagbemi, B.O.; Adetunji, A. Pathogenicity of Eperythrozoon suis alone and when mixed with Babesia trautmanni in experimentally-infected pigs. Vet. Parasitol. 1983, 13, 127–134. [Google Scholar] [CrossRef] [PubMed]
- Portiansky, E.L.; Quiroga, M.A.; Machuca, M.A.; Perfumo, C.J. Mycoplasma suis in naturally infected pigs: An ultrastructural and morphometric study. Pesqui. Veterinária Bras. 2004, 24, 1–5. [Google Scholar] [CrossRef][Green Version]
- Acosta, D.B.; Ruiz, M.; Sanchez, J.P. First molecular detection of Mycoplasma suis in the pig louse Haematopinus suis (Phthiraptera: Anoplura) from Argentina. Acta Trop. 2019, 194, 165–168. [Google Scholar] [CrossRef] [PubMed]
- Toledo, M.A.; Leite, A.I.; Gonçalves, L.R.; Sousa, K.C.; Amaral, R.B.; Silva, G.C.; Machado, R.Z.; André, M.R. High occurrence of Mycoplasma suis infection in swine herds from non-technified farms in Mossoró, state of Rio Grande do Norte, Northeastern Brazil. Rev. Bras. Parasitol. Vet. 2016, 25, 414–417. [Google Scholar] [CrossRef] [PubMed]
- Martins, M.; Silva, L.D.; Miranda, L.M.; Lima, C.A.A.; Amaral, R.B.D.; Machado, R.Z.; André, M.R.; Braga, M.; Rosário, C.; Melo, F.A.; et al. Molecular detection of Mycoplasma suis in extensive pig production systems in the State of Maranhão, northeast Brazil. Rev. Bras. Parasitol. Vet. 2019, 28, 306–309. [Google Scholar] [CrossRef] [PubMed]
- Bordin, L.C.; Gava, D.; Sonalio, K.; Mechler-Dreibi, M.L.; Zanella, J.R.C.; Morés, N.; de Oliveira, L.G.; Vaz, E.K. Investigation of hemotropic Mycoplasmas in fetuses and sows with reproductive failure. Vet. Anim. Sci. 2021, 12, 100175. [Google Scholar] [CrossRef] [PubMed]
- Guimaraes, A.M.; Biondo, A.W.; Lara, A.C.; Messick, J.B. Exploratory study of Mycoplasma suis (Eperythrozoon suis) on four commercial pig farms in southern Brazil. Vet. Rec. 2007, 160, 50–53. [Google Scholar] [CrossRef] [PubMed]
- Ayroud, M.; Leavitt, S.; Higgs, G. Eperythrozoonosis in swine. Can. Vet. J. 1994, 35, 54–55. [Google Scholar] [PubMed]
- Biberstein, E.; Barr, L.; Larrow, L.; Roberts, S. Eperythrozoonosis of swine in New York State. Cornell Vet. 1956, 46, 288–297. [Google Scholar]
- Guimaraes, A.M.; Vieira, R.F.; Poletto, R.; Vemulapalli, R.; Santos, A.P.; de Moraes, W.; Cubas, Z.S.; Santos, L.C.; Marchant-Forde, J.N.; Timenetsky, J.; et al. A quantitative TaqMan PCR assay for the detection of Mycoplasma suis. J. Appl. Microbiol. 2011, 111, 417–425. [Google Scholar] [CrossRef]
- Schweighardt, H.; Fellner, A.; Pechan, P.; Leuermann, E. Eperythrozoonose beim Schwein-ein Fallbericht. Wien. Tierarztl. Mschr. 1986, 73, 250–253. [Google Scholar]
- Schwarz, L.; Strauss, A.; Loncaric, I.; Spergser, J.; Auer, A.; Rümenapf, T.; Ladinig, A. The Stable Fly (Stomoxys calcitrans) as a Possible Vector Transmitting Pathogens in Austrian Pig Farms. Microorganisms 2020, 8, 1476. [Google Scholar] [CrossRef] [PubMed]
- Gattinger, B.; Spergser, J.; Wille-Piazzai, W.; Kolodziejek, J.; Tichy, A.; Joachim, A. Detection of Mycoplasma (Eperythrozoon) suis by real-time PCR. Wien. Tierarztl. Monatsschrift 2008, 95, 22. [Google Scholar]
- De Busser, E.V.; Mateusen, B.; Vicca, J.; Hoelzle, L.; Haesebrouck, F.; Maes, D. Mycoplasma suis infection in suckling pigs on a Belgian farm. Vlaams Diergeneeskd. Tijdschr. 2008, 77, 182–186. [Google Scholar] [CrossRef]
- Normand, V.; Boulbria, G.; Brissonnier, M.; Bachy, V.; Moalic, P.; Berton, P.; Bouchet, F.; Lebret, A. Comparison of qPCR and blood smear microscopy for the diagnosis of Mycoplasma suis in a French veterinary practice. Porc. Health Manag. 2020, 6, 4–7. [Google Scholar] [CrossRef] [PubMed]
- Hoelzle, L.E.; Helbling, M.; Hoelzle, K.; Ritzmann, M.; Heinritzi, K.; Wittenbrink, M.M. First LightCycler real-time PCR assay for the quantitative detection of Mycoplasma suis in clinical samples. J. Microbiol. Methods 2007, 70, 346–354. [Google Scholar] [CrossRef] [PubMed]
- Korn, G.; Mussgay, M. Ein Fall von Eperythrozoon suis mit differentialdiagnostischer Bedeutung bei einem Schweinepestverdacht Zbl. Vet. Med. B 1968, 15, 617–630. [Google Scholar]
- Hoffmann, R.; Saalfeld, K. Ausbruch einer Eperythrozoonose in einem Schweinemastbestand. DTW Dtsch. Tierarztl. Wochenschr. 1977, 84, 7–9. [Google Scholar] [PubMed]
- Müller, E.; Neddenriep, G. Eperythrozoonose in einem Ferkelerzeugerbetrieb in Norddeutschland. Prakt. Tierarzt 1979, 662–665. [Google Scholar]
- Kántás, K.; Andó, P. Eperythrozoonosis in swine in Hungary. Magy. Allatorvosok Lapja 1987, 42, 673–676. [Google Scholar]
- Vezzoli, F.; Gualdi, V.; Luini, M.; Arioli, E.; Botti, S.; Recordati, C. Anaemia and mortality in piglets infected with Mycoplasma suis [Eperythrozoon suis]. In Proceedings of the Atti della Societa Italianà di Patologia ed Allevamento dei Suini 2003 XXIX Meeting Annuale, Salsomaggiore Terme, Italy, 16–19 August 2003. [Google Scholar]
- Perestrelo-Vieira, R.; Heinritzi, K.; Perestrelo-Vieira, H.; Sobestiansky, J.; Abreu-Lopes, J. First diagnosis of Eperythrozoon suis in Portugal. Rev. Port. De Ciências Veterinárias 1997, 92, 14–19. [Google Scholar]
- Potkonjak, A.; Lako, B.; Milićević, V.; Savić, B.; Ivetić, V.; Jakić-Dimić, D.; Stevančević, O.; Toholj, B. Molecular diagnostics of swine infection caused by Mycoplasma suis. Vet. Glas. 2009, 63, 353–358. [Google Scholar] [CrossRef]
- Lako, B.; Potkonjak, A.; Gagrcin, M.; Belic, B.; Stevancevic, O.; Davidov, I.; Toholj, B. Determining the presence and spread of porcine infection with haemotrophic mycoplasmas on our farms. Contemp. Agric. 2009, 58, 1–8. [Google Scholar]
- Gresham, A.; Rogers, J.; Tribe, H.; Phipps, L. Eperythrozoon suis in weaned pigs. Vet. Rec. 1994, 134, 71–72. [Google Scholar] [CrossRef] [PubMed]
- Hoelzle, K.; Engels, M.; Kramer, M.M.; Wittenbrink, M.M.; Dieckmann, S.M.; Hoelzle, L.E. Occurrence of Mycoplasma suis in wild boars (Sus scrofa L.). Vet. Microbiol. 2010, 143, 405–409. [Google Scholar] [CrossRef] [PubMed]
- Santana, M.d.S.; Hoppe, E.G.L.; Carraro, P.E.; Calchi, A.C.; de Oliveira, L.B.; do Amaral, R.B.; Mongruel, A.C.B.; Machado, D.M.R.; Burger, K.P.; Barros-Batestti, D.M. Molecular detection of vector-borne agents in wild boars (Sus scrofa) and associated ticks from Brazil, with evidence of putative new genotypes of Ehrlichia, Anaplasma, and haemoplasmas. Transbound. Emerg. Dis. 2022, 69, e2808–e2831. [Google Scholar] [CrossRef] [PubMed]
- Dias, G.B.; do Amaral, R.B.; Gatto, I.R.H.; Lapera, I.M.; de Oliveira, L.G.; Lux Hoppe, E.G.; Machado, R.Z.; André, M.R. Molecular detection of Mycoplasma suis in captive white-lipped peccaries (Tayassu pecari) and wild boars (Sus scrofa) in Brazil. Comp. Immunol. Microbiol. Infect. Dis. 2019, 63, 94–96. [Google Scholar] [CrossRef] [PubMed]
- Fernandes, A.J.; Elshafie, N.O.; Kmetiuk, L.B.; Ullmann, L.S.; Brandão, A.P.D.; Haisi, A.; van Wilpe Bach, R.; de Barros-Filho, I.R.; Araújo Junior, J.P.; Barbosa, D.S.; et al. Hemotropic mycoplasmas (hemoplasmas) in wild boars, hunting dogs, and hunters from two Brazilian regions. Transbound. Emerg. Dis. 2022, 69, 908–912. [Google Scholar] [CrossRef]
- Heinritzi, K. Untersuchungen zur Übertragbarkeit von Eperythrozoon suis. Tieraerztl. Umsch. 1992, 47, 588–599. [Google Scholar]
- Prullage, J.; Williams, R.; Gaafar, S. On the transmissibility of Eperythrozoon suis by Stomoxys calcitrans and Aedes aegypti. Vet. Parasitol. 1993, 50, 125–135. [Google Scholar] [CrossRef]
- Ade, J.; Ritzmann, M.; Wöstmann, C.; Eddicks, M.; Reese, S.; Hoelzle, K.; Hoelzle, L.E.; Stadler, J. Update on shedding and transmission routes of porcine haemotrophic mycoplasmas in naturally and experimentally infected pigs. Porc. Health Manag. 2021, 7, 49. [Google Scholar] [CrossRef] [PubMed]
- Maes, D.; Nauwynck, H.; Rijsselaere, T.; Mateusen, B.; Vyt, P.; de Kruif, A.; Van Soom, A. Diseases in swine transmitted by artificial insemination: An overview. Theriogenology 2008, 70, 1337–1345. [Google Scholar] [CrossRef] [PubMed]
- Berrier Jr, H.; RE, G. Eperythrozoonosis transmitted in utero from carrier sows to their pigs. J. Am. Vet. Med. Assoc. 1954, 124, 98–100. [Google Scholar] [PubMed]
- Dietz, S.; Mack, S.L.; Hoelzle, K.; Becker, K.; Jannasch, C.; Stadler, J.; Ritzmann, M.; Hoelzle, L.E. Quantitative PCR analysis of Mycoplasma suis shedding patterns during experimental infection. Vet. Microbiol. 2014, 172, 581–585. [Google Scholar] [CrossRef] [PubMed]
- Thiel, W. Zur Pathologie und Diagnostik der Eperythrozooninfektion der Schweine. Prakt. Tierarzt 1983, 64, 692–697. [Google Scholar]
- Thongmeesee, K.; Sri-In, C.; Kaewthamasorn, M.; Thanee, S.; Wattanaphansak, S.; Tiawsirisup, S. Establishment of molecular diagnostics targeting the 23S ribosomal RNA gene for the detection of Mycoplasma suis infection in Thai domestic pigs. Acta Trop. 2023, 238, 106759. [Google Scholar] [CrossRef] [PubMed]
- Ha, S.-K.; Jung, K.; Choi, C.; Ha, Y.; Song, H.-C.; Lim, J.-H.; Kim, S.-H.; Chae, C. Development of in-situ hybridization for the detection of Mycoplasma haemosuis (Eperythrozoon suis) in formalin-fixed, paraffin wax-embedded tissues from experimentally infected splenectomized pigs. J. Comp. Pathol. 2005, 133, 294–297. [Google Scholar] [CrossRef]
- Hoelzle, L.E.; Hoelzle, K.; Ritzmann, M.; Heinritzi, K.; Wittenbrink, M.M. Mycoplasma suis antigens recognized during humoral immune response in experimentally infected pigs. Clin. Vaccine Immunol. 2006, 13, 116–122. [Google Scholar] [CrossRef]
- Hsu, F.S.; Liu, M.C.; Chou, S.M.; Zachary, J.F.; Smith, A.R. Evaluation of an enzyme-linked immunosorbent assay for detection of Eperythrozoon suis antibodies in swine. Am. J. Vet. Res. 1992, 53, 352–354. [Google Scholar] [CrossRef]
- Schuller, W.; Heinritzi, K.; al-Nuktha, S.; Kölbl, S.; Schuh, M. Serologic progression studies using CF and ELISA for the detection of antibodies against Eperythrozoon suis infection of swine. Berl. Munch. Tierarztl. Wochenschr. 1990, 103, 9–12. [Google Scholar]
- Hoelzle, K.; Grimm, J.; Ritzmann, M.; Heinritzi, K.; Torgerson, P.; Hamburger, A.; Wittenbrink, M.M.; Hoelzle, L.E. Use of recombinant antigens to detect antibodies against Mycoplasma suis, with correlation of serological results to hematological findings. Clin. Vaccine Immunol. 2007, 14, 1616–1622. [Google Scholar] [CrossRef] [PubMed]
- Song, Q.; Zhang, W.; Song, W.; Liu, Z.; Khan, M.K.; He, L.; Fang, R.; Li, P.; Zhou, Y.; Hu, M. Seroprevalence and risk factors of Mycoplasma suis infection in pig farms in central China. Prev. Vet. Med. 2014, 117, 215–221. [Google Scholar] [CrossRef] [PubMed]
- Xue, S.; Seo, K.; Yang, M.; Cui, C.; Yang, M.; Xiang, S.; Yan, Z.; Wu, S.; Han, J.; Yu, X.; et al. Mycoplasma suis Alpha-Enolase Subunit Vaccine Induces an Immune Response in Experimental Animals. Vaccines 2021, 9, 1506. [Google Scholar] [CrossRef] [PubMed]
- Hoelzle, K.; Doser, S.; Ritzmann, M.; Heinritzi, K.; Palzer, A.; Elicker, S.; Kramer, M.; Felder, K.M.; Hoelzle, L.E. Vaccination with the Mycoplasma suis recombinant adhesion protein MSG1 elicits a strong immune response but fails to induce protection in pigs. Vaccine 2009, 27, 5376–5382. [Google Scholar] [CrossRef] [PubMed]
Disclaimer/Publisher’s Note: The statements, opinions and data contained in all publications are solely those of the individual author(s) and contributor(s) and not of MDPI and/or the editor(s). MDPI and/or the editor(s) disclaim responsibility for any injury to people or property resulting from any ideas, methods, instructions or products referred to in the content. |
© 2024 by the authors. Licensee MDPI, Basel, Switzerland. This article is an open access article distributed under the terms and conditions of the Creative Commons Attribution (CC BY) license (https://creativecommons.org/licenses/by/4.0/).